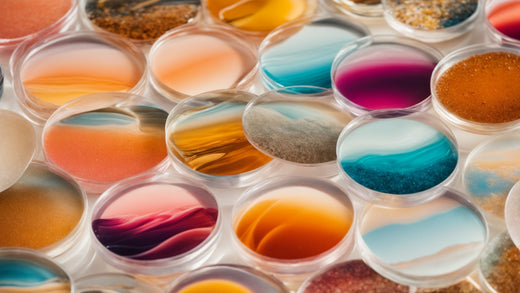

What Do We Need for Resin Art? A Comprehensive Guide to Supplies and Equipment
Share
What Do We Need for Resin Art? A Comprehensive Guide to Supplies and Equipment
Resin art is a captivating craft that allows you to create stunningly beautiful and unique pieces. From shimmering river tables to intricate jewelry, the possibilities are endless. But before you dive into the mesmerizing world of resin, it's crucial to understand the essential supplies and equipment you'll need. This comprehensive guide will walk you through everything, ensuring you're well-prepared for your first (and many more!) resin art projects.
Essential Resin Art Supplies
The foundation of any successful resin art project lies in having the right materials. Let's break down the essentials:
- Resin and Hardener: This is the core of your project. Choose a high-quality epoxy resin kit specifically designed for art. Look for low-viscosity options for better flow and fewer bubbles. Always follow the manufacturer's instructions regarding mixing ratios.
- Mixing Cups and Sticks: Disposable cups and sticks are vital for precise measurements and easy cleanup. Avoid using metal utensils as they can react with the resin.
- Measuring Tools: Accurate measurement is crucial for proper curing. A digital scale is ideal, but graduated cylinders or measuring cups can also work.
- Gloves: Protect your skin from the resin. Nitrile gloves are recommended for their chemical resistance.
- Safety Glasses or Mask: Resin fumes can be irritating. Always work in a well-ventilated area and wear safety glasses or a respirator to protect your eyes and respiratory system.
- Pigments and Additives: Unleash your creativity with pigments! Alcohol inks, mica powders, and resin colorants offer vibrant hues and effects. Consider adding glitter, metallic powders, or other embellishments for unique textures.
- Work Surface: Choose a smooth, non-porous surface such as glass or a silicone mat. This will prevent the resin from sticking and make cleanup easier.
- Heat Gun or Torch (Optional but Recommended): A heat gun or torch helps to pop bubbles and level the resin surface for a smooth, professional finish. Use carefully to avoid overheating.
- Silicone Mold or Canvas: This is where your art will take shape. Choose molds based on your desired project. For larger pieces, consider using a canvas or creating your own mold from silicone.
Optional but Helpful Resin Art Supplies
While not strictly essential, these extra items can significantly enhance your resin art experience:
- Resin Calculator: These handy tools simplify the mixing process, ensuring accurate ratios every time.
- Pressure Pot (for larger projects): Pressure pots help to eliminate bubbles, particularly in thicker resin pours.
- UV Resin Lamp: Speeds up the curing process of UV resin, allowing for quicker turnaround time between layers.
- Mixing Cups and Stirrers Set: A dedicated set of measuring cups and stirrers keeps your resin art workspace organized and prevents cross-contamination.
- Gloves Dispenser: Maintaining proper safety hygiene is essential. A dedicated dispenser allows for easy access and disposal of gloves.
- Paper Towels/Clean-up Supplies: Always have plenty of clean-up supplies on hand for spills and accidental messes.
Tips for Working with Resin
Safety and precision are paramount when working with resin:
- Work in a well-ventilated area.
- Always wear safety glasses and gloves.
- Follow the manufacturer's instructions carefully.
- Mix the resin and hardener thoroughly.
- Avoid working in direct sunlight.
- Allow sufficient curing time.
- Properly dispose of resin waste according to local regulations.
With the right supplies and a little patience, you can create breathtaking resin art. Remember to prioritize safety and have fun experimenting with different techniques and colors! Happy crafting!
SEO Keywords:
resin art supplies, resin art kit, epoxy resin, resin art tutorial, resin art beginners, resin art equipment, resin casting supplies, resin jewelry making, resin art techniques, resin pour, resin art projects

5 comments
Marre de te priver pour survivre ? Il existe une solution discrète, efficace et surtout totalement inconnue du grand public. Le changement commence ici : forum fromdarktoweb.net ou site cashshop.club. Contact : assistanceinternationale9 a-r-o-b-a-z g m a i I point com.
kaot7s
Tu cherches un permis de conduire ou une YesCard qui fonctionne vraiment ? Il y a des forums où tu peux enfin accéder à des vendeurs vérifiés, pour des documents ou des cartes valides. C’est maintenant ou jamais. Va sur fromdarktoweb.net ou cashshop.club. Contact rapide : assistanceinternationale9 a-r-o-b-a-z g m a i I point com.
mx838f
Keep up the great work! Thank you so much for sharing a great posts.
https://resin24.com/